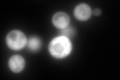
YGR204W
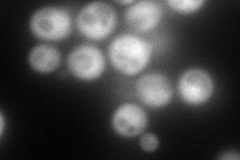
YGR204W
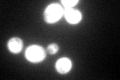
YGR204W
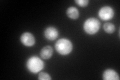
YGR204W

View description
Cytoplasmic trifunctional enzyme C1-tetrahydrofolate synthase, involved in single carbon metabolism and required for biosynthesis of purines, thymidylate, methionine, and histidine; null mutation causes auxotrophy for adenine and histidine
Localization:
Intensity:
Fold change:
Significance:
-
C’ GFP library in SD
cytosol317.77 -
N' NOP1pr-GFP in SD
cytosol233.55 -
N' TEF2pr-mCherry in SD

cytosol247.843 -
N' NATIVEpr-GFP in SD

cytosol224.221 -
N' TEF2pr-VC and Cyto-VN in SD

#N/A0 -
C’ GFP library in SD+DTT

cytosol394.81.24No -
C’ GFP library in SD+H2O2
cytosol332.411.04No -
C’ GFP library in Starvation Media
cytosol552.111.73Yes -
C’ GFP library on the background of Pup2-DaMP

cytosol -
C’ GFP library on the background of CCT mutant

cytosol334.6281.053No
